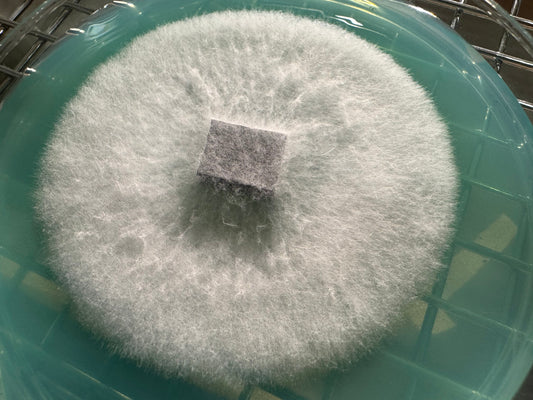

Learn
RF Articles & Blogs
Mushroom Teks & Recipes

How to Make Liquid Culture for Mushrooms
Clear Liquid Culture Recipe This liquid culture (LC) formula combines Light Malt Extract (LME), Corn Syrup, and Soy Peptone to create a nutrient-rich yet clear growth medium. The clarity allows...
How to Make Liquid Culture for Mushrooms
Clear Liquid Culture Recipe This liquid culture (LC) formula combines Light Malt Extract (LME), Corn Syrup, and Soy Peptone to create a nutrient-rich yet clear growth medium. The clarity allows...
The Best Agar Recipe for Mycology (Complete Tek)
This step-by-step guide shows you exactly how to make professional-quality agar plates even if you’ve never done sterile work before. It includes the precise recipe, how to pour at the...
The Best Agar Recipe for Mycology (Complete Tek)
This step-by-step guide shows you exactly how to make professional-quality agar plates even if you’ve never done sterile work before. It includes the precise recipe, how to pour at the...

How to Make Grain Spawn for Mushrooms
How to Make Grain Spawn with Whole Oats Why whole oats? They’re affordable, easy to source, and perform great for species like Lion’s Mane, Oyster, Shiitake, and more. This guide...
How to Make Grain Spawn for Mushrooms
How to Make Grain Spawn with Whole Oats Why whole oats? They’re affordable, easy to source, and perform great for species like Lion’s Mane, Oyster, Shiitake, and more. This guide...